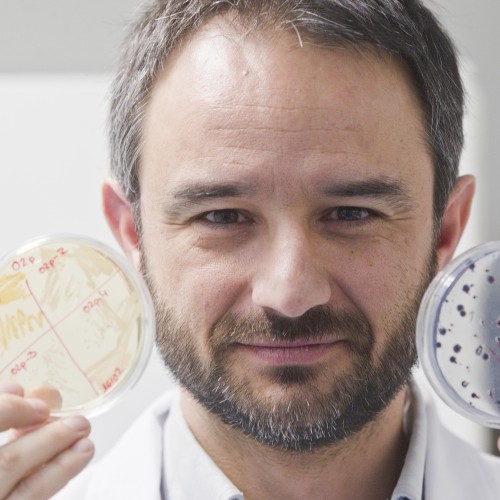

PROGRAMA
Sede del viernes: Fundación Bancaja / Sede del sábado: Edificio B, Universidad Europea Valencia
Ruth Usó
Directora General de Salud Pública
Rosa Sanchidrián Pardo
Rectora Universidad Europea
Verónica Ausina Marquez
Presidenta de SESPO y Comité Organizador
- 9:30| ENCUESTA DE SALUD ORAL EN ESCOLARES DEL PRINCIPADO DE ASTURIAS 2018
José María Blanco González. Jefe de Servicio de Salud Poblacional. Dirección General de Salud Pública y Atención a la Salud Mental. Consejería de Salud del Principado de Asturias. - 9:40| EFICACIA DEL FLUORURO DIAMÍNICO DE PLATA EN EL TRATAMIENTO Y PREVENCIÓN DE LA CARIES DENTAL, TRAS 9 MESES DE SEGUIMIENTO EN ESCOLARES DE CAMERÚN
David Gonzalez Alarcon. Investigador. Circular Research. - 9:50| SALUD BUCODENTAL EN UNA POBLACIÓN INFANTIL DE CAMERÚN
Marcelle Aurore Nadie Ngoh Mankongo. Estudiante. Universidad de Sevilla. - 10:00| DISCROMÍA DENTAL INTRÍNSECA NEONATAL: A PROPÓSITO DE UN CASO CLÍNICO
Agnès Ministral Masgrau. Odontologa. CAP Sarrià de Ter. - 10:10| PREVENCIÓN EN ODONTOLOGÍA INFANTIL. OBJETIVO GENERACIÓN CARIES CERO.
Ana Isabel Gutiérrez Navas. Odontológa. UCAM dental. - 10:20| INTERVENCIÓN EN SALUD COMUNITARIA Y EDUCACIÓN PARA LA SALUD ORAL EN MBOULEMBOU, SENEGAL
Josep Busquet i Vila. Médico estomatólogo. Cap Montilivi / Vila-roja. - 10:30| SALUD ORAL INTEGRAL EN USUARIOS Y NO USUARIOS DE PROGRAMA 60 AÑOS EN DOS COMUNAS DE CHILE
CLaudia Cristoffanini Bonino. Docente. Universidad de los Andes, Santiago de Chile. - PREGUNTAS ONLINE
11:00 - 11:30| CAFÉ - ZONA COMÚN
- 11:30| PROTOCOLO CLÍNICO DE PREVENCION DE LA MORDIDA CRUZADA ANTERIOR
Mila Adobes Martín. Directora Máster Universitario en Ortodoncia Avanzada. Universidad Europea de Valencia. - 11:40| “RELACIÓN ENTRE CARIES DENTAL Y ENFERMEDAD PERIODONTAL EN UNA POBLACIÓN GESTANTE. UN ESTUDIO TRANSVERSAL” "RELATIONSHIP BETWEEN DENTAL CARIES AND PERIODONTAL DISEASE IN A GESTANT POPULATION. A CROSS-SECTION STUDY"
Carla Ros Melián. Estudiante. Universidad de Murcia. - 11:50| DE FÍSTULA ODONTOGÉNICA A CARCINOMA EPIDERMOIDE: LA IMPORTANCIA DEL DIAGNÓSTICO TEMPRANO. A PROPÓSITO DE UN CASO CLÍNICO.
Eva Flores Gudiño. Odontóloga. CAP 17 Setembre. - 12:00| INTELIGENCIA ARTIFICIAL EN ODONTOLOGIA, EN ESPAÑA (2023)
Francesc d'Asis Pérez Pastor. Facultativo. Ib-Salut , Cs Valldargent. - 12:10| “CALIDAD DE VIDA ORAL ENTRE MUJERES GESTANTES PERIODONTALES” "QUALITY OF ORAL LIFE AMONG PERIODONTAL GESTANTIVE WOMEN"
Ana Elena Pérez Rodriguez. Odontóloga. Universidad de Murcia. - 12:20| EFECTO DE LAS FUENTES DE INFORMACIÓN EMPLEADAS POR DENTISTAS EN LA CALIDAD DE PRESCRIPCIÓN DE ANTIBIÓTICOS EN ODONTOLOGÍA
Almudena Rodríguez Fernández. Profesora Docente Investigadora. Universidad de Santiago de Compostela.
- 9:30| EINCORPORACIÓN DE UN NUEVO ROL PROFESIONAL EN LOS EQUIPOS DE ATENCIÓN PRIMARIA: DESPLIEGUE DE LOS HIGIENISTAS DENTALES EN CATALUÑA
Cristina Vida Lucea. Técnica de Salud Pública de la Oficina de Salud Bucodental de la Dirección Estratégica de Atención Primària y Comunitària. Dirección General de Planificación e Investigación en Salud. Generalitat de Catalunya. - 9:35| IMPACTO DE LA INCORPORACIÓN DE LOS HIGIENISTAS DENTALES EN LOS EQUIPOS DE ATENCIÓN PRIMARIA (AP) EN CATALUÑA
Elisabet Caula Pinsach. Técnica de Salud Pública de la Oficina de Salud Bucodental de la Dirección Estratégica de Atención Primaria y Comunitaria, Dirección General de Planificación e Investifación en Salud. Generalitat de Catalunya. - 9:40| LA IMPORTANCIA DE LA EDUCACIÓN ESCOLAR EN LA SALUD ORAL
José Francisco Martín Morales. Profesor contratado doctor. Universidad Complutense de Madrid - 9:45| INTRODUCCIÓN DEL FLUORURO DIAMINO DE PLATA (FDP) COMO HERRAMIENTA TERAPÉUTICA EN LA ODONTOLOGÍA DE ATENCIÓN PRIMARIA EN CATALUNYA
Marta Figueras Cabanes. Odontóloga de atención primaria. Institut Català de la Salut. - 9:50| PRECISIÓN Y UTILIDAD DEL DIAGNODENT EN EL DIAGNÓSTICO DE LA CARIES DENTAL: A PROPÓSITO DE UN CASO .
Germán García Vicent. Odontológo. C.S. Mejorada del Campo. - 9:55| ESTUDIO COMPARATIVO DE TRES MÉTODOS PARA EVALUAR EL RIESGO DE CARIES: CAMBRA, CARIOGRAM Y CARIES RISK SEMAPHORE
José Enrique Iranzo Cortés. Profesor Ayudante Doctor. Universidad de Valencia. - 10:00| DETECCIÓN DE AZÚCARES OCULTOS EN LA DIETA PARA ESTUDIANTES DEL GRADO EN ODONTOLOGÍA.
Ana Ruiz Miravet. Profesora Asociada. Universidad de Valencia. - 10:05| ESTUDIO DE LA RELACIÓN ENTRE LOS TRASTORNOS DEL SUEÑO Y LA OCLUSION DENTARIA EN UNA POBLACIÓN ESCOLAR
Luigi Messina. Profesor Asociado. Facultad de Odontología. Universidad Complutense de Madrid. - 10:10| CASOS CLÍNICOS DE FUSIÓN Y GEMINACIÓN EN DENTICIÓN TEMPORAL. DIAGNÓSTICO Y ALTERNATIVAS DE TRATAMIENTO.
Verónica María Nunes Marinheiro. Estudiante. Facultad de Odontología. Universidad Complutense de Madrid. - 10:15| ANÁLISIS DEL NIVEL DE HIGIENE ORAL Y ESTADO GINGIVAL DE LOS ESCOLARES DE 1º Y 6º DE PRIMARIA DEL BARRIO LA MARINA DE PORT, BARCELONA.
María Terrades Oliver. Dentista de Atención Primaria. Profesora asociada. Institut Català de la Salut. Universitat de Barcelona. - 10:20| INTERVENCIÓN COMUNITARIA PARA LA PREVENCIÓN DE CARIES EN EDADES TEMPRANAS.
Laura Figueroa Marcé. Higienista dental. ABS Salt. - 10:25| EL USO DE VAPEADORES Y SUS RIESGOS PARA LA SALUD ORAL.
Ana Cristina Estop Romero. Higienista bucodental. Dra. Sofia Hernández Montero. - 10:30| IMPORTANCIA EN LA EDUCACIÓN Y MOTIVACIÓN DEL CONTROL DE PLACA MECÁNICO PARA MEJORAR LA SALUD BUCAL EN PACIENTES ADULTOS MAYORES.
Mónica Marina Vindel Castillo. Soporte Clínico. FirstFit. - 10:35| MÉTODOS DE PREVENCIÓN EN TRATAMIENTOS DE IMPLANTES DENTALES PARA PACIENTES DIABÉTICOS.
Gabriela Tesser. Odontólogo Soporte Clínico. FirstFit. - PREGUNTAS ONLINE

Licenciado en Medicina y en Odontología, doctorado en Odontología y Máster en Odontología Preventiva y Comunitaria por la UV. Máster de investigación en Ciencias de la Salud y Máster en Educación Médica por la UAB. Profesor Titular, actualmente Director del Departamento de Estomatología y Secretario del Comité de ética de investigación en humanos de la Universitat de València Ha publicado alrededor de 100 artículos de impacto JCR y codirigido 20 tesis doctorales.
ORAL HEALTH DATA BANK
Interviene en:

Professor Bernabé is a global oral health leader, with experience in generating robust epidemiological evidence to inform health policy and planning. Professor Bernabé has built his international esteem working on understanding the social determinants of oral health inequalities and measuring the burden of oral conditions on individuals and societies. He co-leads the Oral Disorders Collaborators network, which includes over 70 experts worldwide, as part of the Global Burden of Disease Study.
THE BURDEN OF ORAL DISEASSE
Interviene en:
Alejandro Mira es doctor en microbiología por la Universidad de Oxford, Reino Unido. Realizó estancias postdoctorales en EEUU y Suecia, donde se especializó en técnicas genómicas, de microchips y bioinformáticas. En 2009 ganó el premio Jaime Ferrán de investigación en microbiología, que otorga la Sociedad Española de Microbiología, en el 2012 el Premio Biomedal por el primer metagenoma (estudio del ADN) de la placa dental humana a nivel mundial, en 2018 el Premio Nacional FIPSE de Innovación en Salud y en 2019 el Premio de Fomento de la Salud Oral del Consejo General de Dentistas. Actualmente trabaja en la Fundación FISABIO de Valencia, donde dirige el Laboratorio del Microbioma Oral, donde su equipo descubrió la bacteria Streptococcus dentisani. Actualmente investiga la relación entre las bacterias orales y la salud sistémica, como el riesgo cardiovascular o el cáncer.
EL MICROBIOMA ORAL Y SU REPERCUSIÓN EN LA SALUD ORAL Y GENERAL
Interviene en:

Licenciada en Medicina y Cirugía por la UCM.
Médico Especialista en Estomatología, UCM.
Doctora en Medicina y Cirugía, UCM.
Especialista en Programas Preventivos en Enfermedades Bucodentales a Nivel Individual y Público UCM.
Profesor Titular Universidad de la Facultad de Odontología. Universidad Complutense de Madrid, desde 1996.
Vocal de la Comisión Científica de Prevención del COEM desde 2011.
Vicedecana de Grado Facultad de Odontología UCM 2017-2021.
Áreas de Investigación y Proyectos: Factores de Riesgo en Enfermedades Bucodentales y Gestión de Calidad en Odontoestomatología.
Autora de publicaciones a nivel Nacional e Internacional, de capítulos en libros y Dictante de conferencias en Congresos y reuniones científicas.
Directora del Diploma de Especialista en Odontología Preventiva, Comunitaria y Social.
Coordinadora del Vademécum en Odontología Preventiva.
Profesor Titular responsable de la docencia de Odontología Preventiva y Comunitaria de la facultad de Odontología de la UCM desde 2004.
DIAGNÓSTICO DE LAS LESIONES INICIALES DE CARIES: TALENTO Y TECNOLOGÍA
Interviene en:
Anticoagulantes y Antiagregantes en odontología. ¿Cómo actuar?

El Dr. Nicolas Giraudeau es cirujano dentista, profesor en la Universidad de Montpellier y en el Hospital Universitario de Montpellier. Es subdirector del centro de enseñanza e investigación odontológica, responsable del equipo de primera consulta y telemedicina. Tras licenciarse como cirujano dentista (2009), estudió Derecho sanitario en la Facultad de Derecho y Ciencias Políticas de la Universidad de Montpellier y obtuvo un "Máster en Derecho y Gestión de los Establecimientos Sanitarios, Sociales y Médico-sociales", y a continuación redactó una tesis universitaria titulada "El acto médico y la prueba de la telemedicina oral" (2014). Obtuvo la Habilitación para dirigir investigaciones en 2021. Ahora es miembro de un equipo de investigación en ciencias políticas sobre el uso de la tecnología digital en las políticas sanitarias. Está a cargo del programa e-DENT, un programa de telemedicina oral que permite la consulta oral a distancia, en particular para personas con autonomía reducida y personas con discapacidad. También es coordinador del programa "Montpellier Santé Orale". Además, es experto de la OMS en salud digital, miembro del comité de expertos para la creación y redacción del manual del programa mOralHealth de la OMS y colaborador clave del programa mOralHealth. Además, es presidente electo de la red e-Oral Health de la RID y responsable de innovación de la EADPH. Por último, es presidente de la Fundación de la Universidad de Montpellier.
USO DE LA TELEMEDICINA COMO HERRAMIENTA PARA MEJORAR LA ATENCIÓN A LA SALUD ORAL
Interviene en:

Avijit is Professor of Cariology & Operative Dentistry / Hon. Consultant and Clinical Lead, Restorative Dentistry at the Faculty of Dentistry, Oral & Craniofacial Sciences, King's College London / Guy's & St. Thomas' Hospitals Foundation Trust, London, UK. He holds the positions of Chair / Head of Conservative & MI Dentistry and Program Director of the innovative KCL blended-learning Masters in Advanced Minimum Intervention Restorative Dentistry (open to practicing dentists and dental therapists globally: google “KCL AMIRD” for more info). He also leads the Cariology & Operative Dentistry research program at the QS-ranked world's top 10 Faculty of Dentistry (within the research Center of Oral & Clinical Translational Science) as a PI, researching,publishing and lecturing internationally about minimal intervention oral healthcare delivery and minimally invasive operative caries management, dental adhesive biomaterials and clinical trial delivery (>150 peer-reviewed publications, >£2.5 million research grant income, supervision of 5 post-doctorates, 20 doctorates and 25 masters students to date). He currently holds honorary / distinguished chairs in Hong Kong, Valencia (Spain) and the Saveetha Dental College & Hospitals, Chennai, India.
In 2022, he was awarded the prestigious William H Bowen Caries Research Distinguished Scientist Award from the International Association of Dental Research (IADR) in recognition for the global scientific and clinical research impact in this discipline over the last 25 yrs.
He has been appointed to the UK National Institute of Health Research (NIHR) Clinical Research Network, as Oral & Dental Health Specialty Lead for South London where he is responsible for the development of primary care clinical trials and their professional / participant recruitment programmes. He acts as an international R&D KOL for many international dental industry partners, including GC Europe / UK, 3M Oral Healthcare, Septodont France / UK, Dentsply Sirona, Pulpdent, Colgate and Oral B.
Avijit is primary author of Pickard's Guide to Minimally Invasive Operative Dentistry (9th & 10th editions; OUP, 2015; new edition in press (Elsevier - 2024)), a definitive and globally respected text in its field, among other book editorships (Minimally Invasive Esthetics, Elsevier (2015), Odell's Problem Solving in Dentistry, 4th ed, Elsevier (2020)) and further chapter contributions (including, among others, caries management in The Principles of Endodontics 3rd ed, 2019). He is an editor-in-chief of Oral Health & Preventive Dentistry (Quintessence Ltd), Associate Editor of the British Dental Journal and a senior editorial board member of Dental Update, International Journal of Adhesion & Adhesives and the Primary Dental Journal.
He is a senior executive member of the British Dental Association (BDA) Health & Science Committee also, all while maintaining wet-fingered specialist clinical practice in Restorative Dentistry, Prosthodontics & Periodontics. He is a past-President of the BDA Metropolitan Branch London Section (2019-20) and currently holds an Hon. Consultant Advisor post to the Office of the Chief Dental Officer, England (2020 - ). In this role he inputs into national NHS oral & dental care policy direction / advice to the UK government's department of health and social care. He also chairs the Career Pathways Program Board at the new UK College of General Dentistry, helping to develop an integrated system for career development for all oral healthcare team members in primary care.
ODONTOLOGÍA DE MÍNIMA INTERVENCIÓN
Interviene en:

Honorary Professor Colwyn M Jones is the immediate past president of the European Association of Dental Public Health. He is an Honorary Senior Lecturer at the College of Medicine and Veterinary Medicine, University of Edinburgh and recently retired from his role as a Consultant in Dental Public Health
Graduated from the University of Edinburgh Dental School in 1981 and worked as a dentist across the United Kingdom and Denmark before undertaking a Public Health training in Manchester.
He was President of the British Association for the Study of Community Dentistry (BASCD) in 2007/08. From 2010 to 2016 he was Associate Editor of the Community Dental Health Journal.
PROGRAMA CHILD SMILE
Interviene en:

Técnico Superior en Higiene Bucodental
Práctica en clínica privada
Presidenta Federación Española de Higienistas Dentales
Presidenta de la Asociación de Higienistas Dentales de Castilla y León.
Delegada Internacional EDHF (European Dental Hygienist Federation)e IFDH( International Federation Dental Hygienist)
Miembro Comité Responsabilidad Social IFDH
Manager Trainer OHPDH ( Plataforma Europea de Higienistas dentales)
Ponente en Congresos de ámbito Nacional e Internacional : Congreso Nacional de Higienistas HIDES 2022, 2019,2018, 2017,Congreso Multidisciplinar Valencia 2018,Congreso de Pacientes Especiales SEOENE 2017, FDI 2017, Sepa 2016, Jornadas de formación.
Directora y coordinadora del grupo de Responsabilidad Social “ KEEP SMILE “ avalado por la IFDH
Directora y coordinadora de la OLIMPIADA DE HIGIENE BUCODENTAL
Directora Revista Avance en Higiene Bucodental
Miembro Comité Científico de la revista DM
Premio Beca Oral B 2016
Presidenta del 27º y 34º Congreso Nacional de Higienistas Dentales HIDES
Miembro de Comité Organizador y Comité científico en Congresos
Nacionales ( HIDES 2022/2021, , SEOENE 2017,Sepa 2014 )
Voluntaria de AFA ( Asoc. Familiares de Enfremos de Alzheimer)
EL PAPEL DE LOS HIGIENISTAS DENTALES COMO PARTE DEL EQUIPO NECESARIO PARA EL DESARROLLO DE LA ESTRATEGIA MUNDIAL DE SALUD BUCODENTAL DE LA OMS
Interviene en:

Doctora en Enfermería por la Universitat de València (2016), máster en Enfermería Oncológica (2011), Licenciada en Periodismo (2007) y Diplomada en Enfermería (2003).
He desempeñado mi labor como enfermera asistencial en diferentes hospitales y centros de salud, siendo coordinadora de enfermería en uno de ellos. He compaginado mi labor asistencial con la docencia, impartiendo clase como profesora asociada en la Facultat d’Infermeria i Podologia de la Universitat de València. En la actualidad trabajo como enfermera en el centro de salud Malvarrosa.
EL PAPEL DE LA ENFERMERÍA COMUNITARIA EN LA MEJORA DE LA SALUD BUCODENTAL
Interviene en:

Licenciada en Odontología por la Universidad de Murcia en 1999.
Doctor en Odontología Universidad de Murcia 2003.
Máster Universitario en Salud Pública Oral Universidad de Sevilla 2003.
Máster Universitario en Odontología Integrada Infantil. Universidad de Sevilla 2019.
Profesor Contratado Doctor en el Departamento de Dermatología, Estomatología, Radiología y Medicina Física de la Universidad de Murcia.
Directora del Departamento de Dermatología, Estomatología, Radiología y Medicina Física de la Universidad de Murcia (2019/2021).
Actual Secretaria del Departamento de Dermatología, Estomatología, Radiología y Medicina Física de la Universidad de Murcia.
Coordinadora de la asignatura de Odontología Preventiva y Comunitaria, Facultad de Medicina-Odontología, Universidad de Murcia.
Coordinadora de la Asignatura de Odontología de Mínima Intervención, Facultad de Medicina-Odontología, Universidad de Murcia.
Profesor del Instituto de Envejecimiento de la Universidad de Murcia.
Profesor del Máster de Odontología Infantil Integrada de la Universidad de Murcia ( desde 2014 y hasta la actualidad).
Miembro del grupo de investigación “Odontología de Mínima Intervención” del IMIB ( Centro de Investigaciones Biomédicas de la Región de Murcia).
Autora de numerosas publicaciones nacionales e internacionales.
Ponente en Congresos Científicos Nacionales e Internaciones sobre Odontología Preventiva, Odontología de Mínima Intervención y Cariología.
Actual secretaria del Colegio de Dentistas de la Región de Murcia.
Vicepresidenta de la Sociedad Española de Epidemiología y Salud Pública Oral.
Miembro activo de la sociedades científicas: SEDO, SESPO y SEOP, IADP.
ODONTOLOGÍA DE MÍNIMA INTERVENCIÓN
Taller de Materiales para Odontología de Mínima Intervención (OMI)
Interviene en:

Doctor en Medicina y Cirugía
Especialista en Estomatología
Máster en Salud Pública Oral y Especialista Universitario en Atención Primaria
Directora de Cursos de Postgrado y Formación Continuada de la Universitat de València
Coautora de 110 artículos publicados en revista científicas con revisión por pares
Taller de diagnóstico clínico de caries con el sistema ICDAS
Interviene en:

Jefe de Servicio de Cardiología del Hospital Universitario de Sant Joan de Alicante,
Presidente de la Sociedad Valenciana de Cardiología
Presidente de la Sociedad Española de Cardiología.
Presidente de Honor de la Sociedad Española de Cardiología
Presidente de la Comisión Nacional de Cardiología del Ministerio de Sanidad.
Profesor de la Universidad Miguel Hernández, Profesor Titular acreditado por ANECA,
Director del Instituto Internacional de Cardiología de la UCAM
Fellow del American College of Cardiology y de la European Society of Cardiology Governor del Chapter Spain del American College of Cardiology.
Autor de más de 285 artículos, con un factor H de 26, y 40 capítulos de libros.
Anticoagulantes y Antiagregantes en odontología. ¿Cómo actuar?
Interviene en:

- Graduado en Odontología por la Universitat de València con premio extraordinario
- Máster en Endodoncia por la Universitat de València
- Premio Riitano 2020 de la "Accademia Italiana di Endodonzia"
- Premio Catedra IVIO 2020
- Beca FPU del Ministerio de Universidades desde 2021
- Coautor de publicaciones científicas indexadas en revista con revisión por pares
Terapia pulpar vital y endodoncia con materiales biocerámicos
Interviene en:
THE BURDEN OF ORAL DISEASSE
USO DE LA TELEMEDICINA COMO HERRAMIENTA PARA MEJORAR LA ATENCIÓN A LA SALUD ORAL
EL PAPEL DE LA ENFERMERÍA COMUNITARIA EN LA MEJORA DE LA SALUD BUCODENTAL
Terapia pulpar vital y endodoncia con materiales biocerámicos
Taller de diagnóstico clínico de caries con el sistema ICDAS
ORAL HEALTH DATA BANK
EL MICROBIOMA ORAL Y SU REPERCUSIÓN EN LA SALUD ORAL Y GENERAL
DIAGNÓSTICO DE LAS LESIONES INICIALES DE CARIES: TALENTO Y TECNOLOGÍA
EL PAPEL DE LOS HIGIENISTAS DENTALES COMO PARTE DEL EQUIPO NECESARIO PARA EL DESARROLLO DE LA ESTRATEGIA MUNDIAL DE SALUD BUCODENTAL DE LA OMS

Licenciada en Odontología por la Universidad de Murcia en 1999.
Doctor en Odontología Universidad de Murcia 2003.
Máster Universitario en Salud Pública Oral Universidad de Sevilla 2003.
Máster Universitario en Odontología Integrada Infantil. Universidad de Sevilla 2019.
Profesor Contratado Doctor en el Departamento de Dermatología, Estomatología, Radiología y Medicina Física de la Universidad de Murcia.
Directora del Departamento de Dermatología, Estomatología, Radiología y Medicina Física de la Universidad de Murcia (2019/2021).
Actual Secretaria del Departamento de Dermatología, Estomatología, Radiología y Medicina Física de la Universidad de Murcia.
Coordinadora de la asignatura de Odontología Preventiva y Comunitaria, Facultad de Medicina-Odontología, Universidad de Murcia.
Coordinadora de la Asignatura de Odontología de Mínima Intervención, Facultad de Medicina-Odontología, Universidad de Murcia.
Profesor del Instituto de Envejecimiento de la Universidad de Murcia.
Profesor del Máster de Odontología Infantil Integrada de la Universidad de Murcia ( desde 2014 y hasta la actualidad).
Miembro del grupo de investigación “Odontología de Mínima Intervención” del IMIB ( Centro de Investigaciones Biomédicas de la Región de Murcia).
Autora de numerosas publicaciones nacionales e internacionales.
Ponente en Congresos Científicos Nacionales e Internaciones sobre Odontología Preventiva, Odontología de Mínima Intervención y Cariología.
Actual secretaria del Colegio de Dentistas de la Región de Murcia.
Vicepresidenta de la Sociedad Española de Epidemiología y Salud Pública Oral.
Miembro activo de la sociedades científicas: SEDO, SESPO y SEOP, IADP.
ODONTOLOGÍA DE MÍNIMA INTERVENCIÓN
Taller de Materiales para Odontología de Mínima Intervención (OMI)
Interviene en:
PROGRAMA CHILD SMILE

Licenciada en Medicina y Cirugía por la UCM.
Médico Especialista en Estomatología, UCM.
Doctora en Medicina y Cirugía, UCM.
Especialista en Programas Preventivos en Enfermedades Bucodentales a Nivel Individual y Público UCM.
Profesor Titular Universidad de la Facultad de Odontología. Universidad Complutense de Madrid, desde 1996.
Vocal de la Comisión Científica de Prevención del COEM desde 2011.
Vicedecana de Grado Facultad de Odontología UCM 2017-2021.
Áreas de Investigación y Proyectos: Factores de Riesgo en Enfermedades Bucodentales y Gestión de Calidad en Odontoestomatología.
Autora de publicaciones a nivel Nacional e Internacional, de capítulos en libros y Dictante de conferencias en Congresos y reuniones científicas.
Directora del Diploma de Especialista en Odontología Preventiva, Comunitaria y Social.
Coordinadora del Vademécum en Odontología Preventiva.
Profesor Titular responsable de la docencia de Odontología Preventiva y Comunitaria de la facultad de Odontología de la UCM desde 2004.